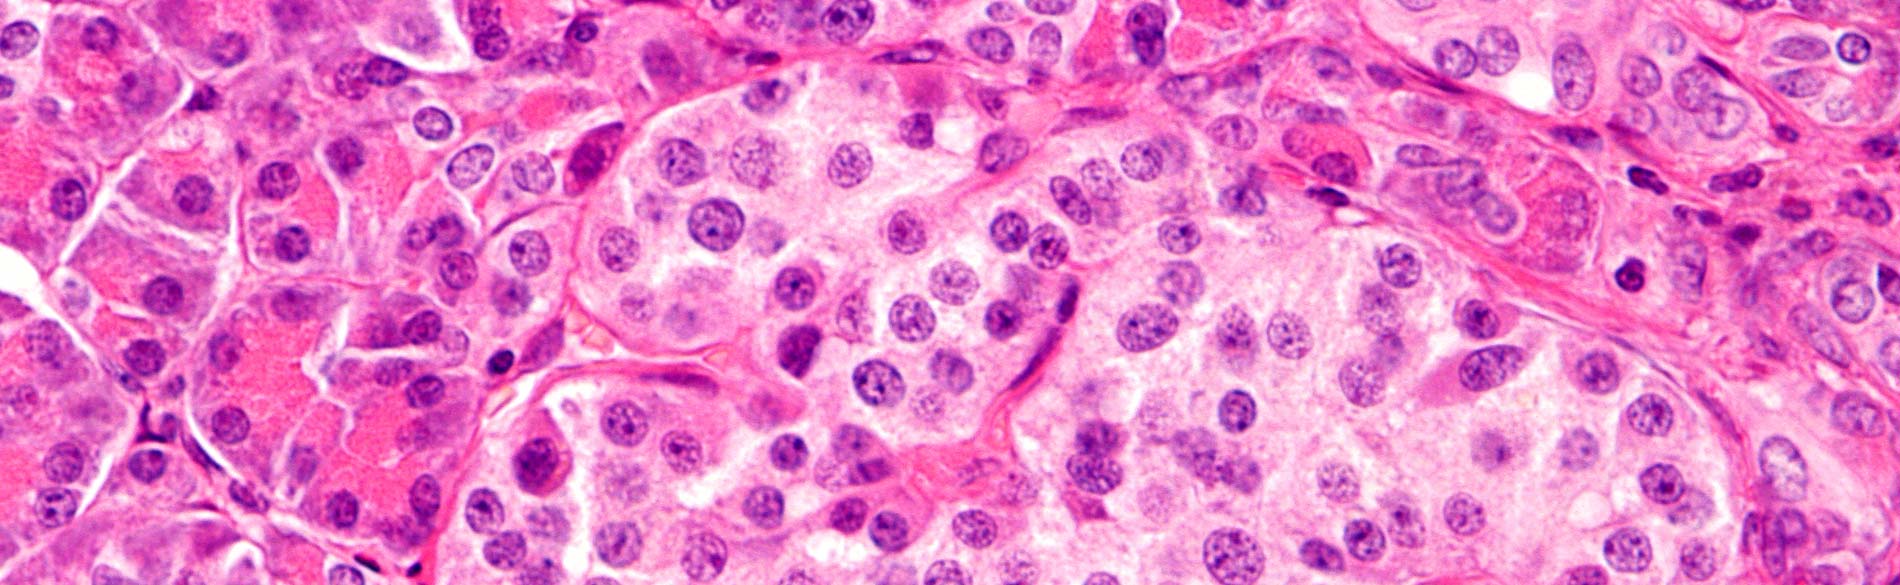

TM
Growing Solutions For Cell Technology
TM
Growing Solutions For Cell Technology
TM
Growing Solutions For Cell Technology
TM
Growing Solutions For Cell Technology
TM
Growing Solutions For Cell Technology
Preserving Life For Tomorrow™
Protide Pharmaceuticals, Inc. is a fully integrated organization devoted to innovative solutions that support research and development in regenerative medicine, cancer biology, cell bioenergy, cancer immunology, translational medicine, epigenetics, and islet cell transplantation.
With over 40 years of innovative products and services, and hundreds of clinical trials using our technology, we positively impact science through knowledge. Inspired by the scientists, patients, and physicians we support, Protide continues as an entrepreneurial, science driven organization.
Be up to date on Protide product announcements and events